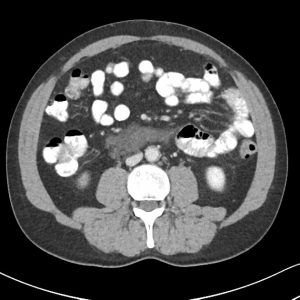
U mạch bạch huyết
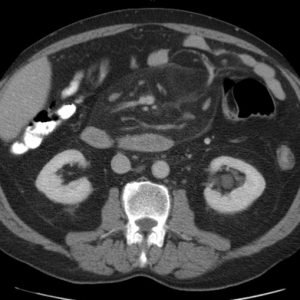
Viêm mạc treo xơ cứng

TIÊU HOÁ
Hiển thị 641–660 của 1445 kết quảĐã sắp xếp theo mới nhất
-

Nang giả tụy
Lượt xem: 246» 02-08-2020 -

Bezoars
Lượt xem: 182» 02-08-2020 -

Viêm bờm mỡ đại tràng
Lượt xem: 149» 01-08-2020 -

Apxe dưới hoành
Lượt xem: 304» 26-07-2020 -

Rò trực tràng – bàng quang
Lượt xem: 349» 21-07-2020 -

U mạch bạch huyết
Lượt xem: 187» 20-07-2020 -

U mỡ mạc treo
Lượt xem: 378» 20-07-2020 -

Viêm mạc treo xơ cứng
Lượt xem: 217» 19-07-2020 -

Viêm mạc treo xơ cứng
Lượt xem: 137» 19-07-2020 -

Viêm mạc treo xơ cứng
Lượt xem: 331» 19-07-2020 -

Viêm mạc treo xơ cứng
Lượt xem: 543» 19-07-2020 -

Viêm mạc treo xơ cứng
Lượt xem: 257» 19-07-2020 -

Viêm mạc treo xơ cứng
Lượt xem: 172» 19-07-2020 -

Viêm mạc treo xơ cứng
Lượt xem: 328» 19-07-2020 -

Thủng tạng rỗng
Lượt xem: 412» 17-07-2020 -

Hẹp môn vị
Lượt xem: 152» 16-07-2020 -

Thoát vị hoành
Lượt xem: 586» 13-07-2020 -

Thiếu máu ruột
Lượt xem: 367» 13-07-2020 -

U mỡ
Lượt xem: 195» 10-07-2020 -

Lồng ruột
Lượt xem: 282» 09-07-2020